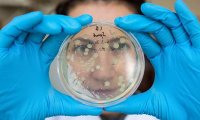
Ученые заявили, что сокращение финансирования исследований угрожает репутации Великобритании

Кирилл Бурлаков: холодная голова в руководстве RBK Money
Недавно RBK.money подключила Yandex Pay – новый сервис Яндекса, причем подключила одной из первых, став технологическим партнером корпорации при отладке и тестировании этого быстрого и удобного...